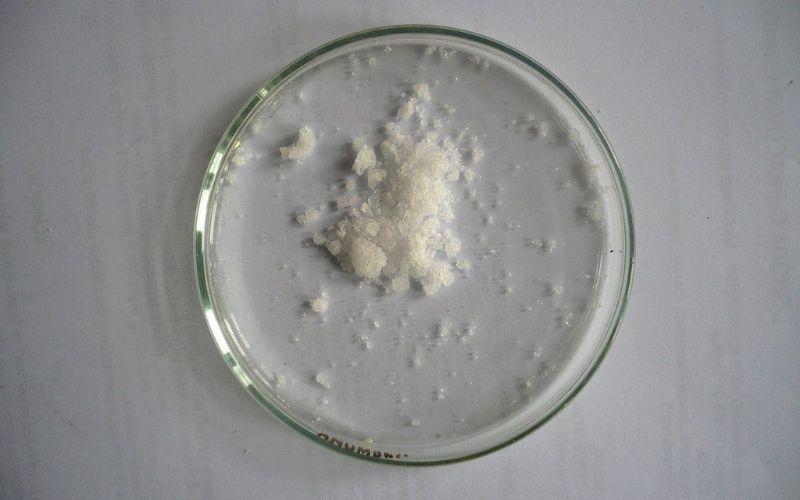

¿Qué es el fosfato de sodio?
El fosfato de sodio es una sal inorgánica cuya fórmula química es Na3PO4. También recibe los nombres de fosfato trisódico (TSP, por sus siglas en inglés: Trisodium Phosphate), o fosfato de sodio tribásico, debido a que carece por completo de la capacidad de donar iones hidrógeno H+.
Cuando se alude a él de manera plural, fosfatos de sodio, se habla de todo el compendio de sales, hidratadas o no, originadas de las interacciones electrostáticas entre el Na+ y el PO43-. Algunas de estas sales inclusive constan de pirofosfatos de sodio, o de polímeros inorgánicos que poseen el PO43- como monómero.
Es por eso que, a menos que se haga una especificación, se referirá siempre al Na3PO4, y no al NaH2PO4, Na2HPO4, Na4P2O7 ni a cualquier otra sal.
En la imagen superior se muestra el aspecto del fosfato de sodio, el cual luce cristales blancos similares a los de la sal común o de mesa, o se compra como un polvo blanco de aspecto amorfo. El Na3PO4 es capaz de formar varios hidratos, siendo el Na3PO4·12H2O el que más se comercializa.
Encuentra uso principalmente en la industria alimentaria, en detergentes, suplementos deportivos, y sirve como laxante hiperosmótico.
Estructura química del fosfato de sodio

La misma fórmula Na3PO4 indica que por cada anión PO43- hay tres cationes Na+. Estos iones pueden observarse en la imagen superior. Nótese que el PO43- tiene geometría tetraédrica, con sus átomos de oxígeno portando una carga negativa resonante, la cual atrae los Na+ del entorno.
Asimismo, la fórmula Na3PO4 señala que se trata de la sal anhidra, por lo que no hay moléculas de agua incluidas en sus cristales. Las atracciones electrostáticas entre el Na+ y el PO43- terminan definiendo un cristal blanco trigonal. Su enlace iónico es tal que el Na3PO4 tiene un punto de fusión de 1.583 °C, considerablemente mayor al de varias sales.
Tanto el Na+ como el PO43- son iones que pueden ser hidratados en sumo grado, sin repercutir negativamente en la estabilidad de los cristales.
Es por esta razón que los hidratos también pueden cristalizar. Sin embargo, sus puntos de fusión son inferiores a los de la sal anhidra, pues los puentes de hidrógeno intermoleculares del agua separan a los iones y debilitan sus interacciones. En el Na3PO4·12H2O, por ejemplo, su punto de fusión es de 73,4 °C, mucho menor que el del Na3PO4.
Propiedades del fosfato de sodio
- Apariencia física. Puede presentarse como cristales blancos definidos o como un polvo o gránulos del mismo color. Todas las magnitudes físicas expresadas a continuación aluden solamente a la sal anhidra Na3PO4.
- Punto de fusión. 1.583 °C.
- Punto de ebullición. 100 °C.
- Solubilidad en agua. 14,5 g/100 mL a 25 °C, por lo cual se le considera un fosfato bastante soluble en agua. No obstante, es insoluble en solventes orgánicos como el etanol y el disulfuro de carbono.
- Densidad. 2,536 g/cm3 a 17,5 °C.
- Estabilidad. Es un sólido higroscópico. Por lo tanto, debe almacenarse de tal modo que no pueda exponerse a la humedad.
- pH. Es una sal fuertemente alcalina. Por ejemplo, una disolución acuosa de la misma al 0,1% ya tiene pH 11,5. Esta propiedad le sirve para que se use como aditivo en los detergentes.
Síntesis del fosfato de sodio
Para sintetizarlo, se parte del ácido fosfórico, H3PO4, o de la sal fosfato diácido de sodio, NaH2PO4.
En la inmensa mayoría de las síntesis se prefiere el H3PO4. Así pues, se hace reaccionar el H3PO4 con una base que neutralice sus tres grupos OH, teniendo en cuenta que este ácido también puede escribirse como PO(OH)3.
La base por preferencia es el hidróxido de sodio, NaOH (en Alemania), pero también es viable (y más económico) utilizar el carbonato de sodio o la ceniza de sosa, Na2CO3 (en Estados Unidos). Las ecuaciones para ambas reacciones de neutralización son:
Na2CO3 + H3PO4 → Na2HPO4 + CO₂ + H₂O
Na2HPO4 + NaOH → Na3PO4 + H₂O
Nótese que al utilizar el Na2CO3 no se obtiene el Na3PO4 sino el Na2HPO4, el cual necesitará de una posterior neutralización. Al ser el medio de reacción acuoso, cristaliza el Na3PO4·12H2O, por lo que debe calcinarse para eliminar su contenido de agua y originar así la sal anhidra.
El Na3PO4·12H2O se caracteriza por “fusionar” sus cristales en una masa compacta difícil de romper. Mientras más pequeño sea el tamaño de sus cristales, más rápida resultará su calcinación.
Usos del fosfato de sodio
- Alimentos. En los usos del fosfato de sodio es inevitable mezclar al Na3PO4 o al Na3PO4·12H2O, pues este último es el hidrato que más se comercializa. Por ejemplo, cualquiera de los dos aporta iones inocuos (en teoría) a los alimentos a los que se adicionan, enriqueciéndolos de fosfatos y aumentando al mismo tiempo su salinidad. En el salar de las carnes, el Na3PO4·12H2O se incluye para mantenerlas frescas por mayor tiempo durante su almacenamiento. Asimismo, se adiciona como agente emulsionante para que la mezcla aceite-agua no se “corte”, sino que permanezca unida, y como un regulador de pH, pues ayuda a disminuir la acidez de los alimentos (entre ellos los cereales). Además, se usa para espesar algunas salsas de tomate, y para el horneado de tortas o panes. Esto último se debe a que el Na3PO4·12H2O tiende a liberar vapor de agua, lo cual aumenta el tamaño de los poros de la masa de harina y el volumen de la misma.
- Detergentes. El fosfato de sodio es lo suficientemente básico para saponificar algunas grasas o aceites con los que tiene contacto. Su alcalinidad se aprovecha entonces para mejorar la acción de los detergentes, siempre y cuando la superficie a desgrasar no sea metálica, pues pueden deteriorarla. No obstante, se han reducido la producción de los detergentes enriquecidos con fosfatos debido a que producen la eutrofización de los lagos y ríos y, con ello, la proliferación de algas que recubren sus superficies. También ha podido usarse para la elaboración de un desinfectante: Na3PO4·1/4NaOCl·11H2O, el cual se prepara utilizando el hipoclorito de sodio, NaOCl, en lugar del NaOH o Na2CO3 para neutralizar el H3PO4.
- Medicinales. El Na3PO4 induce la defecación al actuar como un laxante hiperosmótico, necesario para limpiar el colon antes de que el paciente se someta a una colonoscopía. Por otro lado, también se ha usado (adicionado) en suplementos energéticos.
Referencias
- Shiver & Atkins. Química Inorgánica (Cuarta edición). McGraw Hill.
- Trisodium phosphate. Recuperado de pubchem.ncbi.nlm.nih.gov.
- Trisodium phosphate. Recuperado de en.wikipedia.org.
- Curran, M.P., Plosker G.L. Oral sodium phosphate solution: a review of its use as a colorectal cleanser.
- Sodium Phosphate. Recuperado de healthline.com.